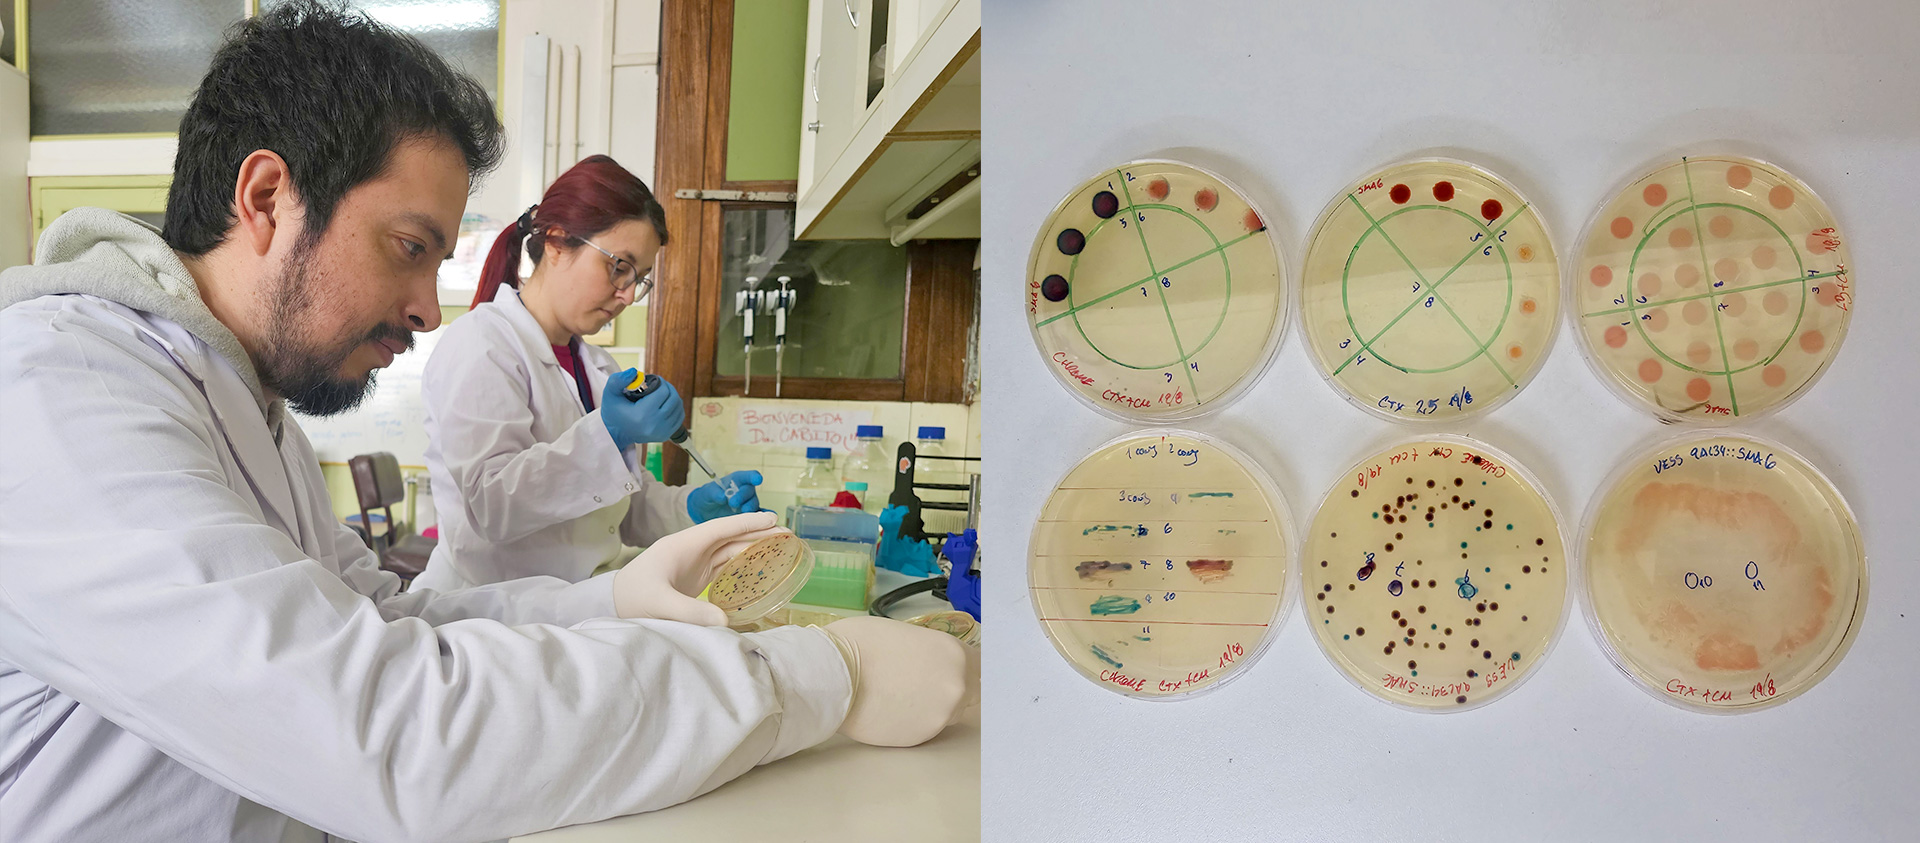

Desarrollo UBA
CÚRCUMA, EL CONDIMENTO QUE PODRÍA MEJORAR LA MEMORIA
Un equipo de la UBA usó nanotecnología para encapsular curcumina y mejorar su absorción, estrategia que potenció la fijación de los recuerdos, en laboratorios. Esto abre vías prometedoras contra enfermedades neurodegenerativas como el Alzheimer.